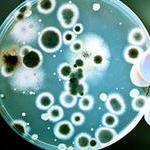
AntibioticResistance (@antibioticresis) 's Twitter Profile Photo

Ausgem
@ausgem2
Australian Centre for Genomic Epidemiological Microbiology - a partnership between NSW Department of Primary Industries and University of Technology Sydney.
ID: 885389021924302848
http://www.ausgem.net 13-07-2017 06:42:47
759 Tweet
271 Followers
274 Following




Good review of World Health Organization (WHO) origins report w/ comments from @edwardcholmes "The most likely has always been, & still remains, an animal to human jump, with bats the most likely point of origin but probably through another animal." smh.com.au/national/austr…

Don’t miss Kevin Outterson, Partnership to Fight Chronic Disease (PFCD)’s Candance DeMatteis, HHS’s Lynn Filpi, and AMR Action Fund’s Silas Holland discuss opportunities to coordinate US actions with international efforts Duke-Margolis #AMR #SquashSuperbugs Register free today: ow.ly/QOKJ50Esx8r




Read the latest Antimicrobial Viewpoint from Stephen Senn (Stephen John Senn) where he discusses the statistical aspects of trials for five #vaccines for #COVID_19 and how their successes can inform #antimicrobial R&D. Link here: bit.ly/3iWwStl


"The results are pretty striking about the lack of access." | John H. Rex, MD, CARB-X's Kevin Outterson & Dr. Samuel Orubu discuss their paper on antibiotic availability in the G7 plus 7 high-income countries in Europe. Watch: 👉t.ly/Jczf👈#antibiotic #AMR



So many new options for #AMR - what are Australians focussing on? Dr Branwen Morgan Dr Audrey Rollin


Australia gives world-first approval for faecal transplants to restore gut health Minimising AMR theguardian.com/australia-news…

New Report from CSIRO that seeks to determine how many Australians die from a drug-resistant infection is finally out #AMR ... it's many more than you think! Dr Branwen Morgan




